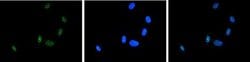
Invitrogen ASH2L Polyclonal Antibody 100 &mu;L; Unconjugated:Antibodies,

missing translation for 'onlineSavingsMsg'
Learn More
Learn More
Invitrogen™ ASH2L Polyclonal Antibody


Rabbit Polyclonal Antibody
Brand: Invitrogen™ PA540070
This item is not returnable.
View return policy
Description
ASH2L Polyclonal Antibody for Western Blot, ICC/IF, ELISA
The human ASH2L gene encodes a 628 amino acid protein known as ASH2L1, or isoform 1, which contains a nuclear localization signal and PHD finger motif, suggesting that the gene product functions as a transcription regulator. Its predicted molecular weight is 68.7kDa. Alternative splicing results in possible isoforms at 60 kDa & 56.5 kDa). Human ASH2L proteins are 60% homologous to Drosophila ash2, which positively regulates expression of certain genes in early development, and contain similar, but not identical, domains, including a zinc finger motif. Homology to mouse ASH2L is 90%. ASH2L is predominantly expressed in adult heart and testis and fetal lung and liver, with barely detectable expression in adult lung, liver, kidney, prostate, and peripheral leukocytes as well as leukemia cell lines with erythroid and megakaryocytic potential, such as K562, Hel and Dami. Differentiation inducers (e.g. phorbol ester and hemin) cause different expression patterns in these cell lines, suggesting that ASH2L plays a role in hematopoiesis and is associated with particular types of leukemia. In addition ASH2L has been suggested to interact with beta-tubulin and beta-catenin.
Specifications
| ASH2L | |
| Polyclonal | |
| Unconjugated | |
| ASH2L | |
| ASH 2; ASH2; ash2 (absent, small, or homeotic)-like; ash2 (absent, small, or homeotic)-like (Drosophila); ASH2 LIKE; ASH2 like histone lysine methyltransferase complex subunit; ASH2 like protein; ASH2 like, histone lysine methyltransferase complex subunit; Ash2l; ASH2L1; ASH2L2; ash2-like; ASH2-like protein; Bre 2; Bre2; set1/Ash2 histone methyltransferase complex subunit ASH2 | |
| Rabbit | |
| 100 μL | |
| Primary | |
| Mouse | |
| Antibody | |
| IgG |
| ELISA, Western Blot, Immunocytochemistry | |
| Conc. Not Determined | |
| whole serum with 0.05% sodium azide | |
| Q91X20 | |
| ASH2L | |
| Three different KLH-conjugated synthetic peptides, 2 containing an amino acid sequence from the central and 1 containing an amino acid sequence from the C-terminal part of the protein corresponding to mouse Ash2 (absent, small, or homeotic 2). | |
| RUO | |
| 23808 | |
| -20°C or -80°C if preferred | |
| Liquid |
Product Content Correction
Your input is important to us. Please complete this form to provide feedback related to the content on this product.
Product Title
Spot an opportunity for improvement?Share a Content Correction